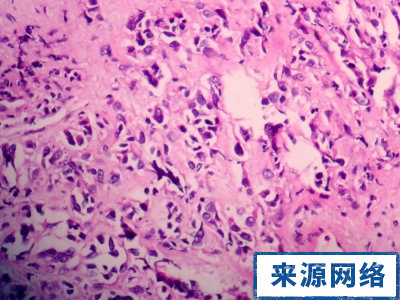
���Ԥ�����װ���

预防措施
①开展群众性的普查工作,尤其对高发人群的普查。
②针对病因采取预防措施,如已经肯定在外来致癌因素中,染料、橡胶、皮革等工种引起膀胱癌的发生,吸烟和服用某些药物,膀胱癌的发病率明显增高,这就要求改善染料、橡胶、皮革等工业的生产条件,提倡禁止吸烟,避免大量、长期服用可致癌的药物。
③高度重视血尿病人的密切随访尤其对40岁以上的男性不明原因的肉眼血尿,原则上要采取严格的措施,包括镑胱镜检查等手段进行膀胱肿瘤的筛选。
④研究工作,包括提高无创伤检查、早期确诊膀胱肿瘤的准确率和研制防治膀胱肿瘤的药物。
预后
膀胱癌的治疗效果与癌肿的类型有密切关系。其中移行上皮细胞癌的治疗效果较好;原位癌是高度恶性细胞,在发生浸润之前治疗效果较好,但一旦发生浸润,则患者的存活率明显下降;膀胱鳞形上皮细胞癌和腺癌均为广基肿瘤,恶性程度高,除手术切除外,对化疗、放疗都不敏感,当前效果差。移行上皮细胞癌的预后又与肿瘤浸润程度的分期有关。
